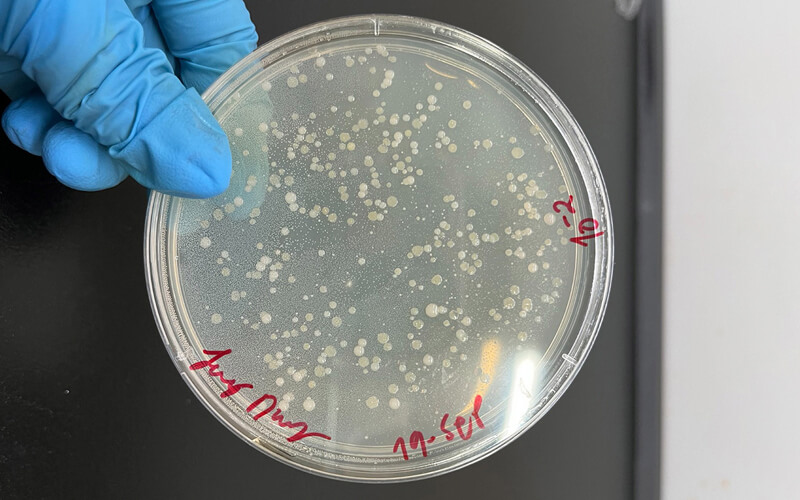
Portada

2025-11-19
Residuos de plátano fermentado son fuente de hidrógeno y energía sostenible
El biohidrógeno resulta de producir hidrógeno con materiales orgánicos o mediante procesos naturales como la fermentación, una alternativa limpia y renovable frente a los combustibles fósiles, y con aplicaciones para fomentar una movilidad sostenible o para generar electricidad limpia. Frente a esto, la Asociación de Hidrógeno y el Consejo Mundial de Energía Colombia destacan que la capacidad de producción de hidrógeno renovable en el país es de 416 toneladas por año.
Con 492.000 hectáreas cultivadas y cerca de 4,9 millones de toneladas al año, el plátano es uno de los productos más importantes del país. Una manera de impulsar estas cifras es aprovechar los residuos del plátano con un enfoque de economía circular, es decir, darles un nuevo uso a materiales que normalmente se desechan para convertirlos en valor y reducir el impacto ambiental.
En ese escenario, Jenny Paola Díaz, magíster en Ciencia y Tecnología de Alimentos de la Universidad Nacional de Colombia (UNAL), comprobó que mediante un proceso de fermentación la pulpa y la cáscara se pueden transformar en hidrógeno natural y de bajo costo.
Esta alternativa pionera en Colombia fortalecería los modelos sostenibles de producción de hidrógeno, pues hoy el 76 % del generado en el país sigue siendo gris, obtenido a partir de gas natural y con alta huella contaminante, mientras un 20 % es azul, también producido con combustibles fósiles pero con captura parcial de sus emisiones, y apenas un 4 % corresponde al hidrógeno verde, obtenido por electrólisis (proceso que mediante electricidad separa las moléculas del agua) y considerado como la opción más limpia.
Frente a estas rutas tradicionales, el método evaluado por la investigadora Díaz parte de fuentes biológicas renovables, lo que abre la puerta a un hidrógeno con huella de carbono neutra, e incluso negativa, incorporando la captura y valorización de los demás residuos del proceso.
De pilar económico a fuente de energía
“La base del proyecto fue la fermentación oscura, un proceso biológico en el que los microorganismos descomponen los azúcares de la fruta y los transforman en compuestos metabólicos como ácidos butírico y acético e hidrógeno, y por último también liberan hidrógeno”, explica la magíster.
Uno de los mayores desafíos en la producción de biohidrógeno es el rendimiento. Para enfrentarlo, a la materia prima se le incorporó un pretratamiento con el fin de degradar componentes como la lignina y así facilitar el trabajo de los microorganismos encargados de generar el hidrógeno.
Sin embargo, este pretratamiento no siempre incrementó la producción, lo que es relevante porque sugiere que los residuos de plátano de Arauca son eficientes por sí solos para llevar a cabo la fermentación. “Evidenciamos que a partir de este residuo se produce hidrógeno, aunque el pretratamiento no siempre aporta a una mayor producción”, afirma la investigadora.
Por ello el proceso se continuó en biorreactores de 20 litros, con un volumen de trabajo de 12 litros, de los cuales 3 kilos correspondían a la fruta y cerca de 9 litros al agua. Durante 72 horas estos ingredientes permanecieron en condiciones estrictamente controladas: ausencia de luz y oxígeno, sin agitación y a temperatura estable.
Posteriormente, durante 4 días más se establecieron las condiciones de acidez (pH), temperatura y agitación para iniciar la etapa de producción del hidrógeno, generando un gas con un contenido máximo de 41,9 % de hidrógeno. El rendimiento fue de 1,16 moles, unidad que determina la cantidad de hidrógeno por mol de azúcar.
Así, el biohidrógeno generado tiene una aplicabilidad directa, hecho que se evidenció cuando, al final de la etapa de producción, se pudo hacer combustión y apareció una llama azul característica, demostrando que la mezcla gaseosa es capaz de liberar energía de inmediato.
Y aunque el gas se puede purificar después para obtener hidrógeno de mayor pureza, el hecho de que la mezcla inicial ya sea combustible amplía su potencial para usos directos en campo, por ejemplo para generar calor o electricidad de forma local, continua y sostenible.
Una alternativa económica viable
Una de las principales ventajas de la fermentación oscura es su viabilidad económica: utiliza residuos agroindustriales y requiere equipos mucho más asequibles que el método convencional de electrólisis, que demanda alta inversión y un consumo elevado de energía eléctrica. Además, el 38 % del residuo del plátano queda sin aprovechar tras la cosecha, lo que representa una oportunidad real para transformarlo en energía y reducir un problema ambiental recurrente en zonas productoras.
En departamentos como Arauca, en donde la alta producción ha generado la acumulación de grandes volúmenes de desechos y riesgos para el ambiente y la salud pública, este tipo de bioconversión es especialmente pertinente. De hecho, el uso de estos residuos no solo mitigaría dicho problema, sino que además se integraría a los sistemas locales de energía como alternativa renovable, particularmente en zonas rurales no interconectadas, en donde el biohidrógeno impactaría directamente en la autonomía energética de las comunidades.
Así, este método de producción se podría implementar directamente en campo, allí donde se concentra la actividad platanera, democratizando la generación de energía limpia, fomentando la economía circular y fortaleciendo la autosuficiencia energética en regiones productoras como Arauca, que supera las 36.000 hectáreas sembradas según el Instituto Colombiano Agropecuario.

Unimedios | Agencia de Noticias UN
La Unidad de Medios de Comunicación – Unimedios, es la unidad de producción y difusión de la información científica, cultural, investigativa, académica, artística y tecnológica generada por la Universidad Nacional de Colombia y dirigida a la comunidad universitaria y a la sociedad en general. Es una dependencia de nivel nacional, adscrita a la Rectoría que articula los medios de comunicación existentes dentro de la Unidad para velar por el buen nombre e imagen de la Institución, promover y agenciar sus logros e integrarla en su diversidad y con la sociedad a través de sus medios, servicios y productos.